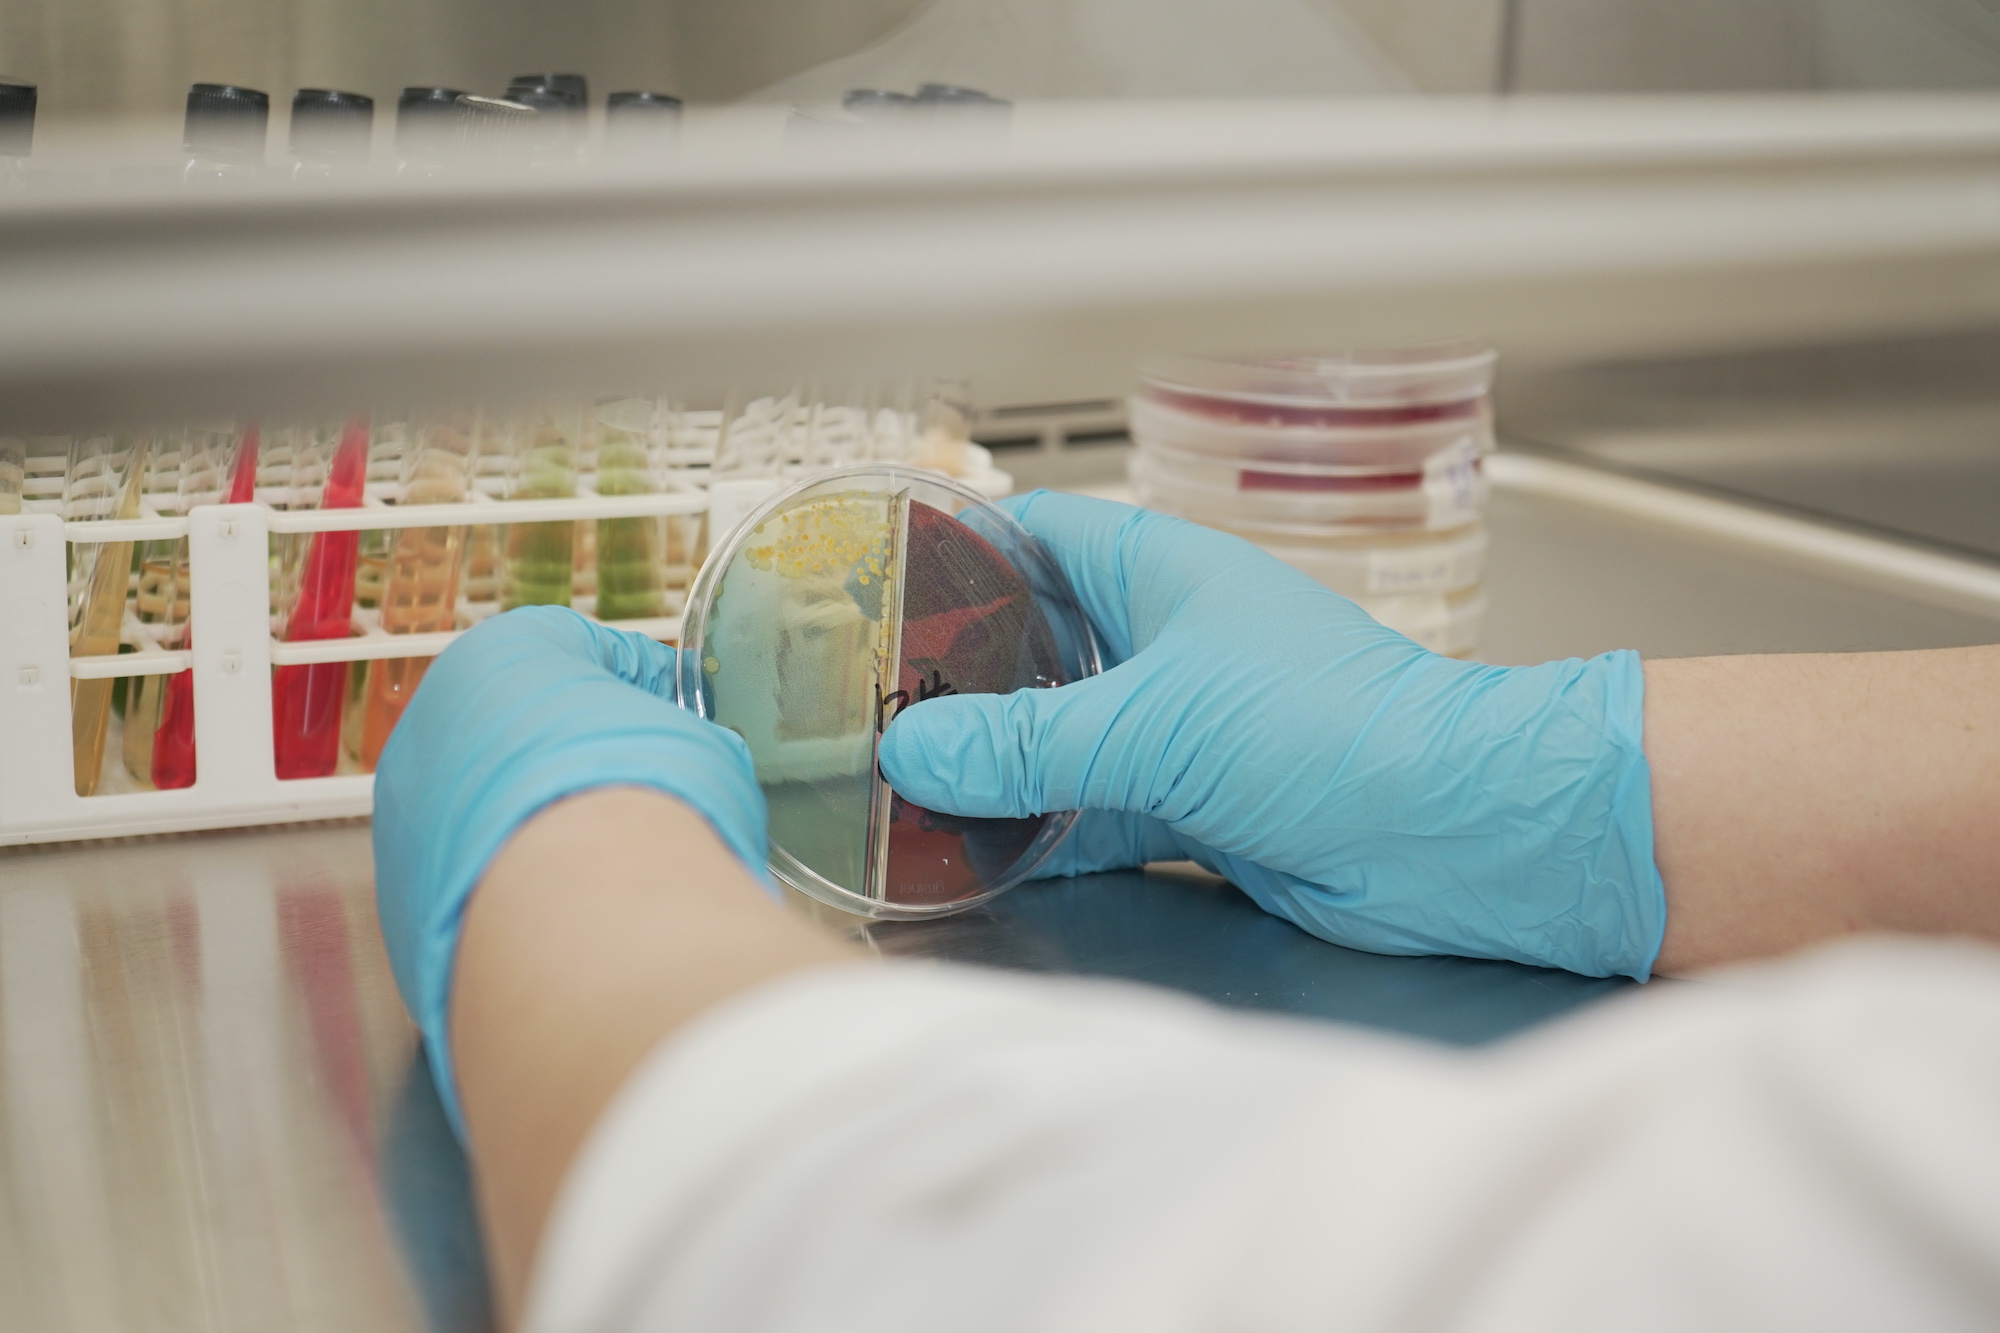

Descripción
La Facultad de Ciencias Químicas pone a consideración su trabajo académico, investigativo y de vinculación con la sociedad, desarrollado a través de la práctica de una docencia de calidad, investigación e innovación en su área de estudio.
Desde su oficio de conocimiento se permite contribuir a la sociedad con cuatro carreras: Bioquímica y Farmacia, Ingeniería Química, Ingeniería Ambiental e Ingeniería Industrial. Su carta de presentación en la Academia, la coloca como una dependencia dinámica, donde confluye la solidez de una trayectoria de más de sesenta años.
Aquí se trabaja en una continua formación de pregrado y posgrado de la más alta calidad, mediante la mejora continua con la innovación y a la vanguardia de las ciencias químicas.
Grado
Bioquímica y Farmacia
Esta carrera combina el estudio de la bioquímica, el análisis biológico y la aplicación práctica de la farmacología. Las y los estudiantes aprenden sobre la composición de los seres vivos, el funcionamiento de los sistemas biológicos, la síntesis y el diseño de fármacos para tratar enfermedades. Esto les permite participar activamente en el equipo de salud del Sistema Nacional de Salud (SNS) y en la industria alimentaria.
Reseña
Los ambientes de aprendizaje están equipados con laboratorios de física, química, biología, parasitología, hematología, inmunología, biología molecular, análisis clínico y de alimentos, entre otros. Los estudiantes pueden realizar prácticas preprofesionales en el Laboratorio Clínico de Atención al Público y llevar a cabo proyectos de investigación y titulación en el departamento de Biociencias, así como en el Orquideario de la Universidad de Cuenca. Además, existen convenios con instituciones públicas y privadas, como laboratorios, farmacias e industrias de alimentos, para que los estudiantes puedan desarrollar sus habilidades en entornos reales.
Campo Ocupacional
-
Analista en laboratorios de análisis bioquímico clínico y microbiólogo.
-
Analista de toxicología en centros forenses y de criminalística, en laboratorios de biología molecular, en centros de investigación en diagnóstico paraclínico de laboratorio, entre otros.
-
Farmaceútico/a con capacidad para la formulación, preparación de recetas magistrales, producción, distribución, control de calidad, gestión del medicamento, marketing y atención farmacéutica, validación de métodos y procedimientos farmacéuticos conforme a buenas prácticas de manufactura.
Datos Generales
Título:
Bioquímico/a Farmacéutico/a
Tiempo:
10 ciclos / 5 años
Modalidad:
Presencial
Ingeniería Ambiental
Esta carrera forma profesionales capaces de resolver los problemas ambientales generados por actividades humanas y productivas, que protejan los ecosistemas y mejoren la calidad de vida de la población.También, podrán reconocer, interpretar, diagnosticar y proponer soluciones integradas a impactos ambientales de acuerdo a las leyes medioambientales vigentes.
Reseña
Prepararamos a las y los estudiantes para crear soluciones sostenibles que protejan y mejoren la calidad del medio ambiente, reduzcan problemas como la contaminación del agua, aire y suelo, gestionen residuos y conserven los recursos naturales. Además, podrán poner en práctica los conocimientos adquiridos y diagnosticar el estado actual de los recursos naturales en nuestros laboratorios.
Campo Ocupacional
-
Al finalizar su formación, las y los graduados de Ingeniería Ambiental podrán:
-
-
Abordar los desafíos ambientales de manera ética, crítica y sostenible, aplicando fundamentos científicos, tecnológicos y de ingeniería para diagnosticar, prevenir, mitigar y resolver problemas relacionados con el agua, el aire, el suelo, los residuos y los ecosistemas, contribuyendo al desarrollo sostenible.
-
-
Diseñar, evaluar e implementar soluciones técnicas y de gestión ambiental, incluyendo auditorías, procesos de licenciamiento, planes de manejo, sistemas de gestión ambiental basados en ISO 14001, estrategias de economía circular, producción más limpia y herramientas para la sostenibilidad organizacional.
-
-
Gestionar integralmente los recursos naturales y los sistemas ambientales, con capacidades en hidrología, meteorología, climatología, manejo integral del agua, ordenamiento territorial, gestión de cuencas y conservación ambiental, apoyando la toma de decisiones en contextos públicos y privados.
-
-
Diseñar y optimizar tecnologías y procesos para el tratamiento, control y remediación de contaminantes y residuos, cumpliendo la normativa ambiental vigente y respondiendo a estándares nacionales e internacionales en calidad ambiental y sostenibilidad.
-
-
Aplicar herramientas avanzadas de análisis, monitoreo y modelación ambiental, utilizando SIG, sensores remotos, drones, AutoCAD 3D, lenguajes de programación como R y Python, análisis de datos, simulación e inteligencia artificial para la evaluación y gestión de sistemas ambientales complejos.
-
-
Participar y liderar procesos de investigación, innovación y desarrollo tecnológico, orientados a mitigar impactos ambientales, fortalecer la resiliencia territorial, enfrentar el cambio climático y generar soluciones basadas en evidencia científica.
-
-
Impulsar estrategias de sostenibilidad, huella de carbono, criterios ESG y certificación ambiental, promoviendo prácticas responsables en organizaciones, territorios y proyectos, con visión interdisciplinaria y compromiso con la conservación del medio ambiente.
-
-
Formular, evaluar, gestionar y dirigir proyectos ambientales, integrando componentes técnicos, regulatorios, económicos y sociales, con capacidad para desempeñarse en consultoría, gestión pública, empresa privada, academia e investigación.
Datos Generales
Título:
Ingeniero/a Ambiental
Tiempo:
10 ciclos / 5 años
Modalidad:
Presencial
Ingeniería Industrial
Esta carrera forma profesionales competentes para el diseño, control, administración y mejoramiento continuo de sistemas de producción de bienes y/o servicios en el área de gestión de operaciones y manufactura, calidad ,proyectos y seguridad industrial para impulsar el desarrollo empresarial sustentable.
Reseña
Preparamos a estudiantes en las ciencias de ingeniería y en la administración de sistemas de producción, analizando factores como materiales, maquinaria, instalaciones, personas y energía. El ambiente de aprendizaje incluye laboratorios de termodinámica, control, máquinas y cómputo. Las y los estudiantes podrán poner en práctica sus conociemientos dentro empresas de producción de bienes y servicios locales como PYMEs, bancos, hospitales, servicios municipales, entre otros.
Campo Ocupacional
-
Administración de pequeñas y medianas empresas
-
Responsable de Planeamiento Estratégico y Organizacional de la Empresa
-
Responsable de Investigación y Desarrollo de Productos y Proceso
-
Gestión del desarrollo en su propia empresa
-
Ejecución de Planificación y control de la producción
-
Responsable de la cadena de distribución de la empresa
-
Administración de los sistemas integrados de gestión
-
Administración de Recursos humanos
-
Asesoría gerencial
-
Consultoría empresarial e industrial
Datos Generales
Título:
Ingeniero/a Industrial
Tiempo:
10 ciclos / 5 años
Modalidad:
Presencial
Ingeniería Química
Esta carrera forma profesionales capaces de controlar procesos industriales que involucran cambios físicos, químicos y bioquímicos, para impulsar el desarrollo industrial del país de manera sostenible y eficiente. Además, pueden aportar a la transformación de materiales y energía, con calidad, seguridad y respeto el medio ambiente.
Reseña
Preparamos a los y las estudiantes para que comprendan los procesos en los que la materia experimenta un cambio de composición. Además, aprenden cómo se pueden utilizar estos procesos para producir materiales metálicos y polímeros, productos químicos, medicamentos, cosméticos, papel, fibras textiles, petróleo y sus derivados, biotecnología y el tratamiento de aguas, así como todo aquello que tenga un componente tecnológico en estos sectores. El ambiente de aprendizaje incluye acceso a laboratorios y plantas piloto de la carrera, así como a plantas industriales y artesanales, y a software especializado en aplicaciones propias de la Ingeniería Química, como MATLAB, AUTOCAD, ASPEN PLUS y ASPEN HYSIS.
Campo Ocupacional
-
Gerencia de Calidad y Operaciones.
-
Supervisión en plantas de producción a nivel industrial.
-
Dirección en departamentos de investigación y desarrollo.
-
Dirección o análisis en laboratorios.
-
Dirección, Capacitación y Técnicos en empresas públicas como: Ministerio del Ambiente, CGA, GADS Municipales.
-
Integración de equipos multidisciplinarios en áreas técnicas y administrativas.
Datos Generales
Título:
Ingeniero/a Químico/a
Tiempo:
10 ciclos / 5 años
Modalidad:
Presencial
Historia
Como facultad independiente nace en 1954 con las escuelas de «Química y Farmacia» y de «Química Industrial». Luego evolucionó de acuerdo a los eventos que marcaron la demanda de profesionales. En el año 1960 se cambia la denominación de la escuela de «Química y Farmacia » a la de » Bioquímica y Farmacia». Màs adelante, en el año 1978 se modifica el nombre de la carrera de «Química Industrial» con un nuevo pénsum a la carrera de «Ingeniería Química». Recientemente en el año de 1997, se crea la escuela de «Ingeniería Industrial». Por otro lado, la Escuela de Ingeniería Ambiental fue creada bajo resolución del Honorable Consejo Universitario en fecha 8 de julio de 2008, por solicitud del Honorable Consejo Directivo de la Facultad de Ciencias Químicas y por recomendación del Consejo de Planificación.
Autoridades

Dr. María Eulalia Peñafiel
Decano

Ing. Fernando García
Vicedecana
Docentes

Ing. Albuja Arias Daniela Alexandra, MSc.
Docente

Ing. Alvarez Lloret Edgar Paul, MS.
Docente

Master en métodos numéricos para el calculo y diseño en ingeniería. Docente periodo académico septiembre 2025 – febrero 2026.

Ing. Alvarez Lloret Edgar Paul, MS.
Docente

Master en métodos numéricos para el calculo y diseño en ingeniería. Docente periodo académico septiembre 2025 – febrero 2026.

Ing. Alvarez Palomeque Lourdes Ximena, MS.
Docente

Ing. Alvarez Palomeque Lourdes Ximena, MS.
Docente
Facultad de Ciencias Químicas
ORCID
0000-0001-6724-7997Magister en Gestión Ambiental para Industrial de Producción y Servicios. Docente periodo académico septiembre 2025 – febrero 2026.

Ing. Andrade Muñoz Diana Jesús, MSc.
Docente

Ing. Andrade Tenesaca Dolores Susana, PhD.
Docente

Ing. Arcentales Carrión Rodrigo Nicanor, PhD.
Docente

Ing. Arcentales Carrión Rodrigo Nicanor, PhD.
Docente
Facultad de Ciencias Químicas
Doctor en Ciencias de la Administración. Docente periodo académico marzo – agosto 2025.

Ing. Arias Cisneros James Marlon, MS.
Docente

Magister en Gestión Tecnológica. Docente periodo académico septiembre 2025 – febrero 2026.

Ing. Astudillo Alemán Ana Lucía, MSc.
Docente

Ing. Astudillo Ochoa Gonzalo Javier
Docente

Ing. Astudillo Ochoa Sonia Margoth
Docente

Ing. Astudillo Segovia Servio Rodrigo
Docente

Ing. Astudillo Zuñiga Jorge Israel
Docente

Ing. Aviles Añazco Alex Manuel
Docente

Ing. Barragan Landy Milton Francisco, PhD.
Docente

Ing. Barragan Landy Milton Francisco, PhD.
Docente
Facultad de Ciencias Químicas
PhD in Industrial and Systems Enginnering. Docente periodo académico septiembre 2025 – febrero 2026.

Ing. Bernal Pesántez Edison Bolivar
Docente

BQF. Bustamante Pacheco Freddy Enrique
Técnico Docente

Técnico Docente periodo académico septiembre 2025 -febrero 2026.

BQF. Bustamante Pacheco Freddy Enrique
Técnico Docente

Técnico docente periodo académico septiembre 2025 – febrero 2026.

BQF. Bustamante Pacheco Freddy Enrique
Técnico Docente

Técnico docente periodo septiembre 2025 – febrero 2026.

Ing. Cabrera Quito Juana María
Docente

Ing. Carrillo Rojas Galo José, PhD.
Docente

Ing. Cisneros Ramos Juan Fernando
Docente

Ing. Cordero Ahiman Otilia Vanessa, PhD.
Docente

Ing. Cordero Ahiman Otilia Vanessa, PhD.
Docente
Facultad de Ciencias Químicas
Doctora en Economía Agraria Alimentaria y de los Recursos Naturales. Docente periodo académico septiembre 2025 – febrero 2026.

CPA. Polo Moreira María Paz. MS.
Docente

CPA. Polo Moreira María Paz. MS.
Docente
Facultad de Ciencias Químicas
ORCID
0000-0001-9115-1610Magister en Contabilidad y Finanzas con Mención en Gerencia y Planeamiento Tributario. Docente periodo académico marzo – agosto 2025.

Ing. Criollo Bravo Jessica Ximena
Docente

Ing. Cruzat Contreras Christian Américo
Docente

Ing. Cuenca León Jaime Estuardo
Docente

Ing. Cuzco Quizhpi Nancy Mirian
Docente

Ing. Delgado Noboa Jorge Washington
Docente

Ing. Donoso Moscoso Silvana Patricia
Docente

Dra. Cazar Ramírez Maria Elena, PhD.
Docente

Ing. Durán López María Elisa
Docente

Ing. Escandón Quezada Denisse Estefania, MS.
Docente

Magister en Seguridad e Higuiene Industrial. Docente periodo académico marzo – agosto 2025.E

Ing. Espinoza Hernández Paulina Rebeca, MS.
Docente

Ing. Espinoza Hernández Paulina Rebeca, MS.
Docente
Facultad de Ciencias Químicas
ORCID
0000-0001-9416-5225Magister en Sistema Integrados de Gestión de la Calidad, Ambiente y Seguridad. Docente periodo académico septiembre 2025 – febrero 2026.

Ing. Espinoza Hernández Paulina Rebeca, MS.
Docente

Ing. Espinoza Hernández Paulina Rebeca, MS.
Docente
Facultad de Ciencias Químicas
ORCID
0000-0001-9416-5225Magister en Sistemas Integrados de Gestión Integrados de la Calidad, Ambiente y Seguridad. Docente periodo académico septiembre 2025 – febrero 2026.

Fís. Mejía Guamán Christian Fernando, PhD.
Docente

Fís. Mejía Guamán Christian Fernando, PhD.
Docente
Facultad de Ciencias Químicas
PhD- Doutor em Ciencias Fisica. Docente periodo académico septiembre 2025 – febrero 2026.

Ing. Flores Siguenza Pablo Andrés, PhD.
Docente – Investigador

Ing. Flores Siguenza Pablo Andrés, PhD.
Docente – Investigador
Facultad de Ciencias Químicas
PhD en Ingeniería Industrial. Docente periodo académico septiembre 2025 – febrero 2026.

Ing. Flores Zamora Damián Vicente
Docente

Ing. Goercke Torres Sonia Amayra
Docente

Ing. Guamán Guachichullca Noe Rodrigo, MBA.
Docente – Director de la Carrera de Ingeniería Industrial.

Ing. Guamán Guachichullca Noe Rodrigo, MBA.
Docente – Director de la Carrera de Ingeniería Industrial.
Facultad de Ciencias Químicas
Magister en Administración de Empresas con mención en Logística y Transporte. Docente periodo académico septiembre 2025 – febrero 2026.

Ing. Guaman Ortiz Franklin Eduardo, MS.
Docente

Magister en Ciencias Naturales y Matemáticas. Docente periodo académico septiembre 2025 – febrero 2026.

Ing. Guaman Ortiz Franklin Eduardo, MS.
Docente

Magister en Ciencias Naturales y Matemáticas. Docente periodo académico septiembre 2025 – febrero 2026.

Ing. Guanuchi Quito Alexandra Elizabeth, MS.
Docente

Ing. Guanuchi Quito Alexandra Elizabeth, MS.
Docente
Facultad de Ciencias Químicas
Master Universitario en Ingeniería Hidráulica y Medio Ambiente.

Ing. Guanuchi Quito Alexandra Elizabeth, MS.
Docente

Ing. Guanuchi Quito Alexandra Elizabeth, MS.
Docente
Facultad de Ciencias Químicas
Master Universitario en Ingeniería Hidráulica y Medio Ambiente.

Ing. Guanuchi Quito Juan Carlos, MS.
Docente

Ing. Guanuchi Quito Juan Carlos, MS.
Docente
Facultad de Ciencias Químicas
ORCID
0009-0002-0898-1088Master Universitario en Ingeniería Ambiental – Especialidad en Dirección de Estaciones de Depuración de Aguas Residuales – Especialidad en Gestión Ambiental en la Industria. Docente periodo académico marzo – agosto 2025.

Ing. Guanuchi Quito Juan Carlos, MS.
Docente

Ing. Guanuchi Quito Juan Carlos, MS.
Docente
Facultad de Ciencias Químicas
ORCID
0009-0002-0898-1088Master Universitario en Ingeniería Ambiental – Especialidad en Dirección de Estaciones de Depuración de Aguas Residuales – Especialidad en Gestión Ambiental en la Industria. Docente periodo académico marzo – agosto 2025.

Ing. Iñiguez Morán Andrea María, MBA
Docente

Magister en Administración de Empresas. Docente periodo académico septiembre 2025 – febrero 2026.

Ing. Iñiguez Morán Andrea María, MBA
Docente

Magister en Administración de Empresas. Docente periodo académico septiembre 2025 – febrero 2026.

Ing. Jadán Avilés Diana Carolina, MS.
Docente

Ing. Jadán Avilés Diana Carolina, MS.
Docente
Facultad de Ciencias Químicas
Master of Science in Management of Logistics and Production Systems. Docente periodo académico septiembre 2025 – febrero 2026.

Ing. Jerves Cobo Rubén Fernando
Docente

Ing. Jiménez Herraez Gabriela Noemi
Docente

Lcdo. Astudillo Banegas José Efraín, PhD
Docente

Lcdo. Cardenas Calle Miguel Alberto, MSc.
Docente

Ing. Llivisaca Villazhañay Juan Carlos, MS.
Docente

Ing. Llivisaca Villazhañay Juan Carlos, MS.
Docente
Facultad de Ciencias Químicas
Magister en Estadística Aplicada, Ciencias Naturales, Matermáticas y Estadística. Docente periodo académico septiembre 2025 – febrero 2026.

Ing. López Cisneros Carmen Lucía
Docente

Ing. Montaleza Auquilla María Magdalena
Docente

Ing. Montero Izquierdo Iván Andrés, PhD.
Docente

Ing. Montero Izquierdo Iván Andrés, PhD.
Docente
Facultad de Ciencias Químicas
PhD – Doctorado en Tecnologías de Climatización y Eficiencia Energética en Edificios. Docente periodo académico marzo – agosto 2025.

Ing. Montero Izquierdo Iván Andrés, PhD.
Docente

Ing. Montero Izquierdo Iván Andrés, PhD.
Docente
Facultad de Ciencias Químicas
PhD – Doctorado en Tecnologías de Climatización y Eficiencia Energética en Edificios. Docente periodo académico marzo – agosto 2025.

Ing. Montero Izquierdo Iván Andrés, PhD.
Docente

Ing. Montero Izquierdo Iván Andrés, PhD.
Docente
Facultad de Ciencias Químicas
PhD – Doctorado en Tecnologías de Climatización y Eficiencia Energética en Edificios. Docente periodo académico marzo – agosto 2025.

Ing. Moscoso Vanegas Diana Lucia
Docente

Ing. Narváez Buestán Freddy Eduardo, MSc.
Docente

Ing. Narváez Buestán Freddy Eduardo, MSc.
Docente
Facultad de Ciencias Químicas
ORCID
0000-0003-3877-8080Magister en Métodos Matemáticos y Simulación Numérica en Ingeniería. Docente periodo académico septiembre 2025 – febrero 2026.

Ing. Ochoa Castro Maritza Raphaela
Docente

Ing. Orellana Cobos Ana Belén
Docente

Ing. Peláez Samaniego Manuel Raúl, PhD.
Docente

Ing. Peláez Samaniego Manuel Raúl, PhD.
Docente
Facultad de Ciencias Químicas
PhD – Doctor of Philosophy – Docencia, Investigación y Gestión en Educación Superior. Docente periodo académico septiembre 2025 – febrero 2026.

Ing. Peña González Silvia Alexandra, PhD.
Docente

Ing. Peña González Silvia Alexandra, PhD.
Docente
Facultad de Ciencias Químicas
PhD – Doctora en Ingeniería de Producción, Área de Concentración, Investigación Operativa e Intervención en Sistemas Sociotécnicos – Docencia, Investigación y Gestión en Educación Superior. Docente periodo académico septiembre 2025 – febrero 2026.

Ing. Peña González Silvia Alexandra, PhD.
Docente

Ing. Peña González Silvia Alexandra, PhD.
Docente
Facultad de Ciencias Químicas
PhD – Doctora en Ingeniería de Producción, Área de Concentración, Investigación Operativa e Intervención en Sistemas Sociotécnicos – Docencia, Investigación y Gestión en Educación Superior. Docente periodo académico septiembre 2025 – febrero 2026.

Psic. Jerves Mora Rodrigo Saúl, MS.
Docente

Psic. Jerves Mora Rodrigo Saúl, MS.
Docente
Facultad de Ciencias Químicas
ORCID
0000-0002-0126-2032Magister en Psicoterapia del Niño y la Familia. Docente periodo académico 2025 – febrero 2026.

QFB. Barrera Parra Diana Alexandra
Docente

QFB. Cabrera Andrade Andrea Alexandra
Docente

QFB. Criollo Bravo Diana Alexandra
Docente

Ing. Ramírez Jimbo Patricia Liliana
Docente

Ing. Rojas Quinde Jenny Maritza, MS.
Técnica Docente


Ing. Sánchez Alvarracin Carlos Mauricio, MS.
Docente

Ing. Sánchez Alvarracin Carlos Mauricio, MS.
Docente
Facultad de Ciencias Químicas
Magister en Métodos Numéricos y Simulación Numérica en Ingeniería. Docente periodo académico septiembre 2025 – febrero 2026.

Ing. Sánchez Alvarracin Carlos Mauricio, MS.
Docente

Ing. Sánchez Alvarracin Carlos Mauricio, MS.
Docente
Facultad de Ciencias Químicas
Magister en Métodos Numéricos y Simulación Numérica en Ingeniería. Docente periodo académico septiembre 2025 – febrero 2026.

Ing. Sánchez Alvarracin Carlos Mauricio, MS.
Docente

Ing. Sánchez Alvarracin Carlos Mauricio, MS.
Docente
Facultad de Ciencias Químicas
Magister en Métodos Numéricos y Simulación Numérica en Ingeeniería. Docente periodo académico septiembre 2025 – febrero 2026.

Ing. Uguña Rosas María Fernanda
Docente

Ing. Vanegas Peña Paúl Fernando, MBA.
Docente

Ing. Vanegas Peña Paúl Fernando, MBA.
Docente
Facultad de Ciencias Químicas
Master en Administración Industrial. Docente periodo académico septiembre 2025 – febrero 2025.

Ing. Vanegas Peña Paúl Fernando, MBA.
Docente

Ing. Vanegas Peña Paúl Fernando, MBA.
Docente
Facultad de Ciencias Químicas
Master eb Administración Industrial. Docente peridodo académico septiembre 2025 – febrero 2026.

Ing. Vidal Davila Juan Carlos, MS.
Docente

Master Universitario en Ingeniería, Matemática y Computación. Docente periodo académico marzo – agosto 2024.

Ing. Vidal Davila Juan Carlos, MS.
Docente

Master Universitario en Ingeniería, Matemática y Computación. Docente periodo académico marzo – agosto 2024.

Ing. Vintimilla Álvarez Paola Fernanda, MS.

Ing. Vintimilla Álvarez Paola Fernanda, MS.
Facultad de Ciencias Químicas
Master Universitario en Ingeniería Avanzada de Producción, Logística y Cadema de Suministro, el la Especialidad Profesional Logística y Transporte. Docente periodo académico septiembre 2025 – febrero 2026.

Ing. Zamora Matute Cristian Eduardo, PhD.
Docente

Ing. Zamora Matute Cristian Eduardo, PhD.
Docente
Facultad de Ciencias Químicas
ORCID
0009-0008-0797-0129PhD – Doctor en Ciencias Administrativas. Docente periodo académico septiembre 2025 – febrero 2026.

Ing. Zamora Matute Cristian Eduardo, PhD.
Docente

Ing. Zamora Matute Cristian Eduardo, PhD.
Docente
Facultad de Ciencias Químicas
ORCID
0009-0008-0797-0129PhD – Doctor en Ciencias Administrativas. Docente periodo académico septiembre 2025 – febrero 2026.